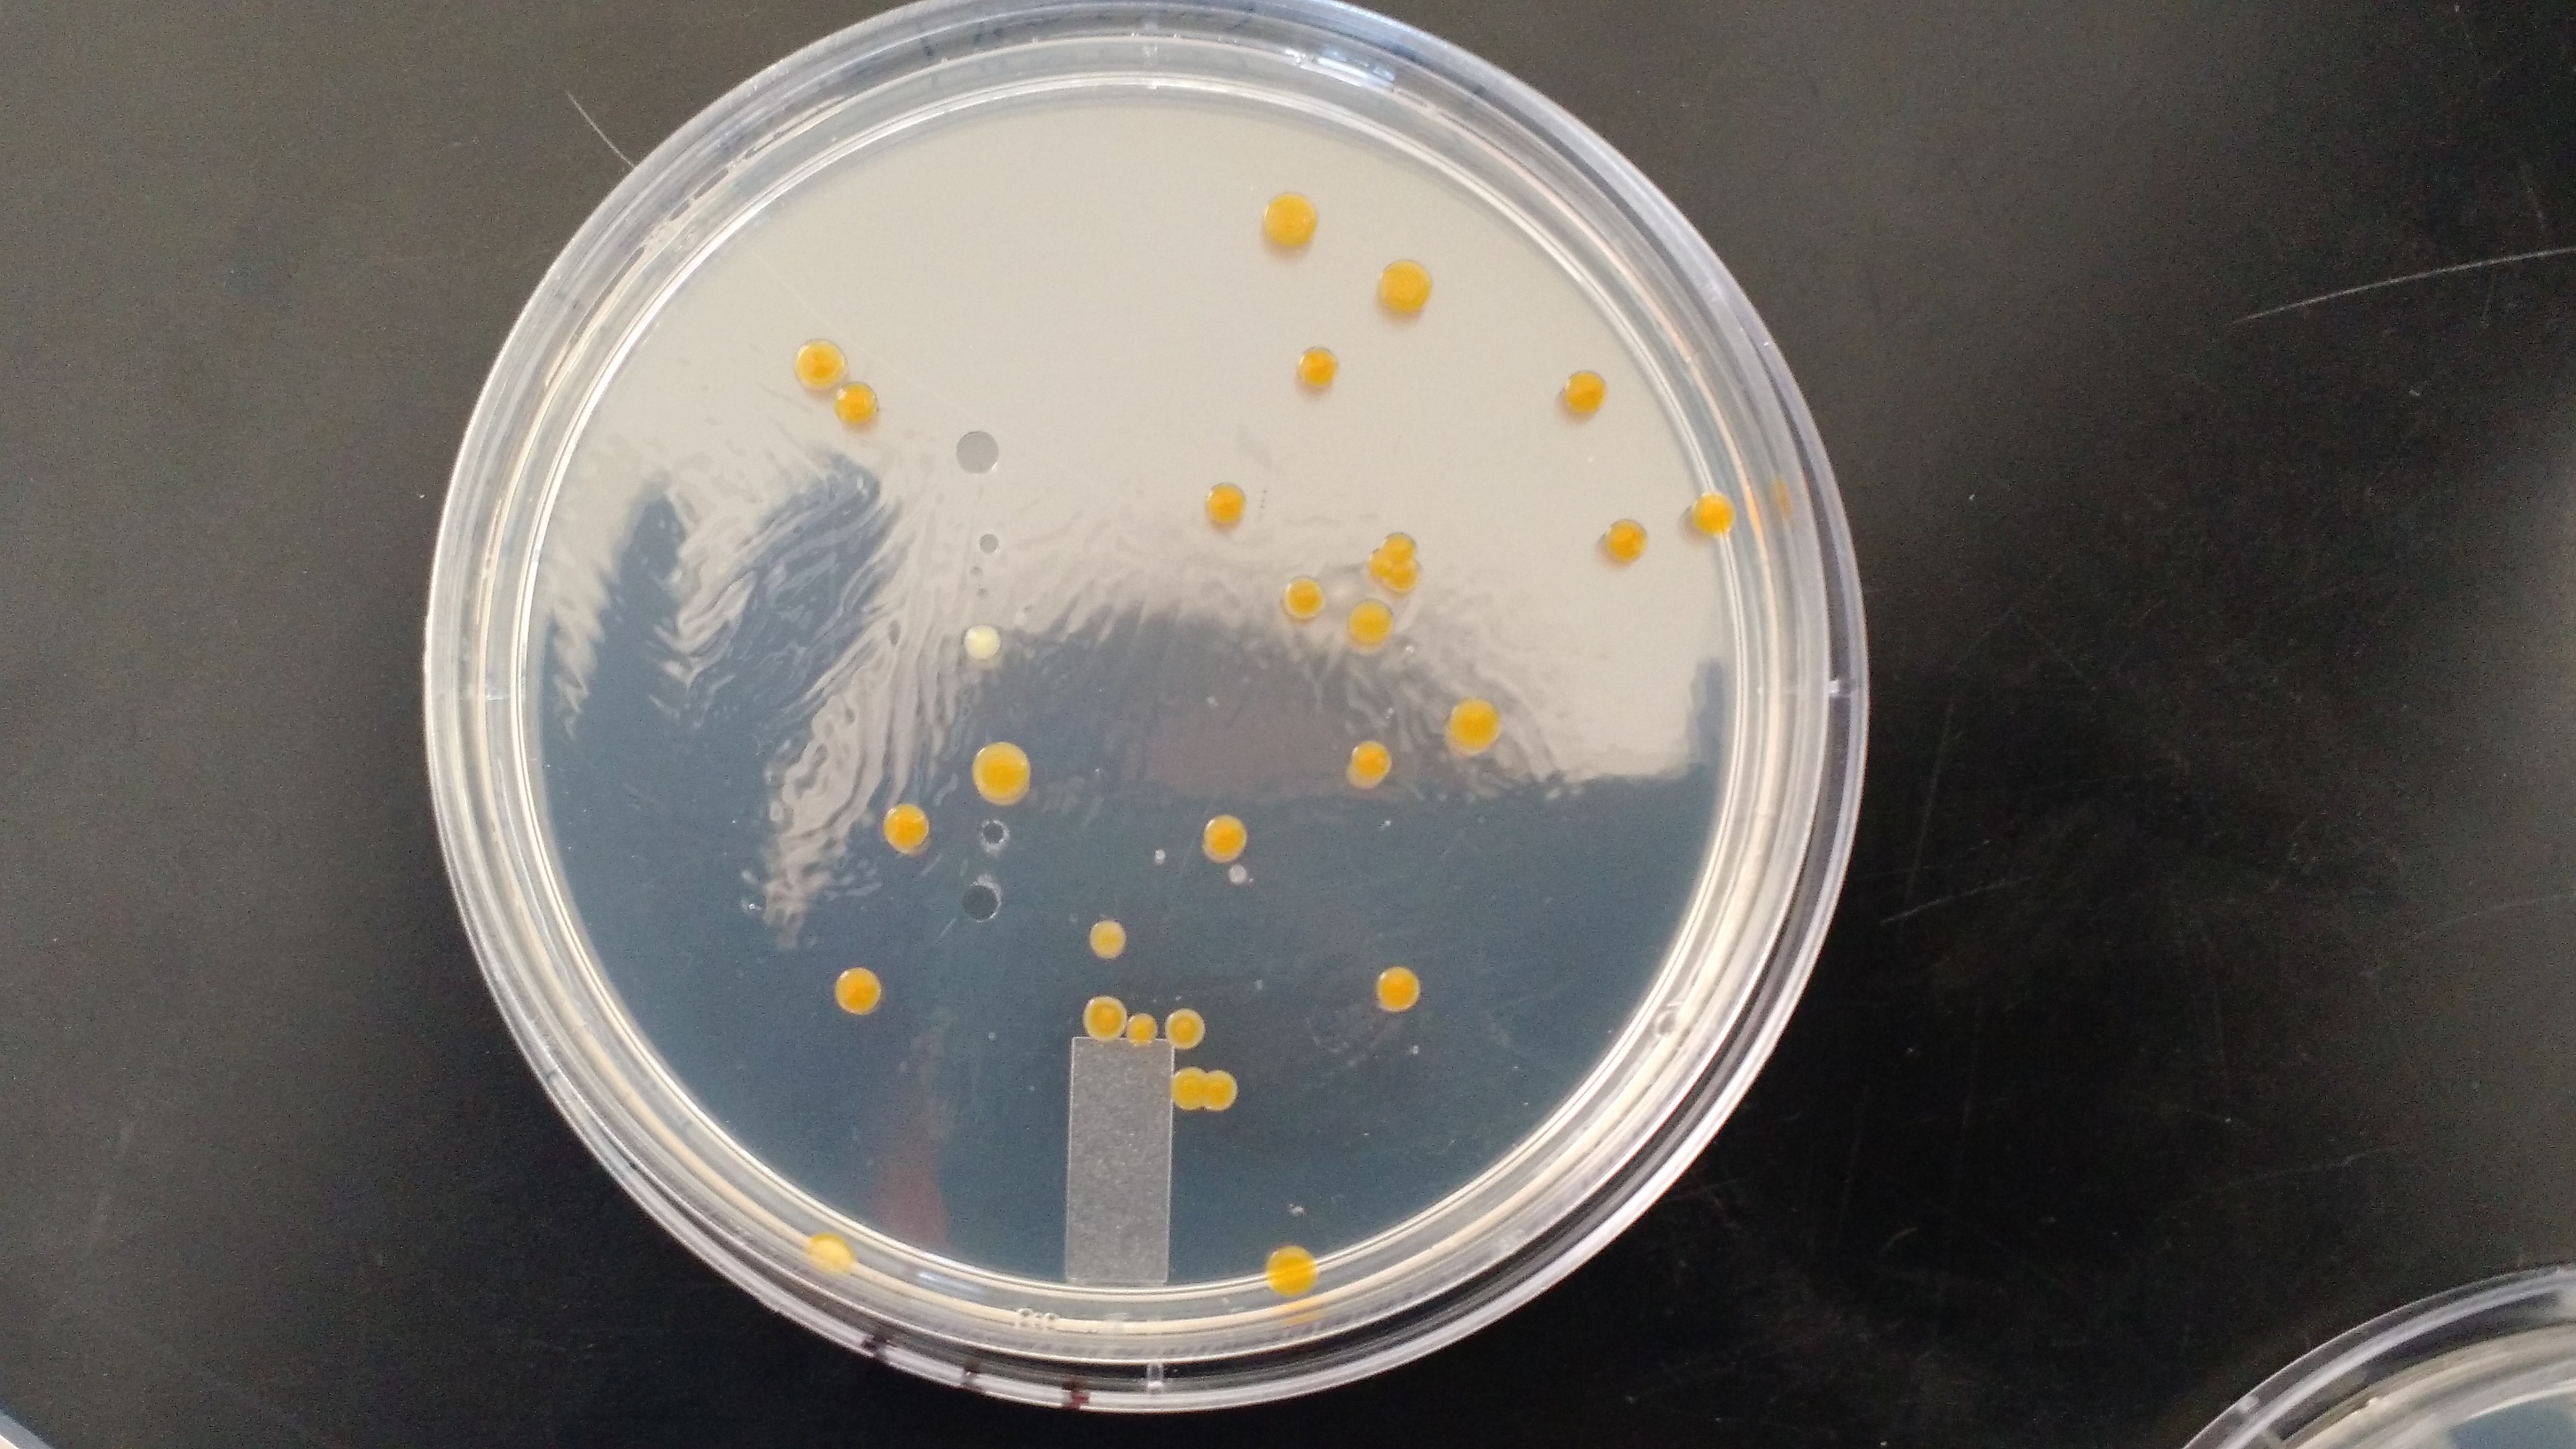

User:Katrina Wakeman/Notebook/Biology 210 at AU
Bacteria DNA Sequencing Results
3/3/16
Purpose: In a previous lab, the DNA from two bacteria colonies grown from a sample from transect one, was isolated and ampliphied throuhg PCR. The PCR did not yeild results. Therefore, two DNA sequences that were found in transect 1 by a previous lab were examined. The purpose was to identify which organism they most closely matched to try to identify them.
Materials and Methods Sequencing results taken from a lab notebook written by a student who observed transect 1 in a previous class. This sequence was run through an online program to find all the different organisms that were a close match, and how closely they matched.
Results:
DNA Sequence from White Bacteria Colony on Nutrient Plates

DNA Sequence from White Bacteria Colony on Tetracycline Plates

The sequence for the bacteria found on the nutrient plate most closely matched Pseudomonas fluorescens and the sequence for the bacteria found on the tetracycline plate most closely matched Ralstonia pickettii.
Conclusion: It is likely that both Pseudomonas fluorescens and Ralstonia pickettii inhabit transect 1. However, as the results were obtained by a third party, it is impossible to know if their procedure was done correctly or if there was bias introduced.
Final Zebra Fish Data Collection
3/3/16
Purpose:
The purpose of this lab was to make final observations on the affects that metaprolol, epinephrine and a metaprolol and epinephrine mixture have on the development of zebra fish. This data, along with the data collected from the previous two weeks, will be used to either support or refute that hypothesis that if metaprolol and epinephrine have individual effects on the Zebra Fish, then these effects will either be compounded or, if they are opposite, they will cancel each other out, in the Zebra Fish treated with the mixture of epinephrine and metaprolol.
Materials and Methods: February 29, 2016, the number of dead fish in each treatment was recorded. The lengths 3 fish from each treatment were measured and recorded, Observations on the fish’s’ movements were taken and photos were taken of a fish from each treatment. This method was repeated on March 2, 2016 and March 3, 2016 except no length measurements were taken on March 2, 2016. March 3, 2016, 2 fish from the control group and the epinephrine were removed with a transfer pipet and put into separate glass vials. Each fish was anesthetized for about five minutes, then 2 mLs of formaldehyde was added. It was not possible to preserve specimens from the metaprolol and mix group because all the fish had already died and decayed. The length, eye diameter and head size was measured for each specimen that had been preserved. This included specimens preserved on February 25, 2016 from each treatment group, specimens preserved on February 24, and 29, 2016 from the metaprolol group, and specimens preserved on March 3, 2016 from the control group and the epinephrine group.
Results:
Conclusion: Based on the data describing the movements and behavior of the fish, the epinephrine treated fish seemed the healthiest out of the four treatments. The epinephrine group presented more movement overall and as a response to stimuli. Additionally, the least amount of deaths were observed in the epinephrine group. The control group was the next healthiest group. They presented slightly less movement than the epinephrine group which is logical, based on the fact that epinephrine is a stimulant. Additionally, They had more deaths than epinephrine but significantly less deaths than metaprolol or the mix group. The metaprolol group had the worst health and the mix group was only slightly better. Both had very little movement in response to stimuli and both populations died off before the end of the experiment. However, the metaprolol group all died earlier than the mix group, and while both were still alive, the mix group showed slightly more movement.
This data does support the hypothesis that if metaprolol and epinephrine have individual effects on the Zebra Fish, then these effects will either be compounded or, if they are opposite, they will cancel each other out, in the Zebra Fish treated with the mixture of epinephrine and metaprolol. The epinephrine caused heightened movement and health while the metaprolol suppressed movement and lowered the health of the fish. The mix group had slightly more movement than the metaprolol but much less than the epinephrine. Additionally they were slightly more healthy than the metaprolol but much less healthy than the epinephrine. This suggests that the effects of the metaprolol were much stronger than the effects of the epinephrine. Therefore, the epinephrine somewhat, but not entirely, canceled out the effects of the metaprolol. Further analysis of the data will be presented in a full lab report turned in to the TA.
Zebra Fish Experimentation Continued
'3/2/16
Purpose:
The purpose of this lab was to continue to observe the affects that metaprolol, epinephrine and a metaprolol and epinephrine mixture have on the development of zebra fish. The hypothesis remains that (enter Hypothesis)
Materials and Methods: It was decided that the zebra fish in the well plates had all started out to unhealthy, which resulted in a high mortality rate. Due to this above average mortality rate, in comparison to the petri dish fish, the well plates and fish were discarded and just the petri dish fish were examined starting February 25th, or the 8th day of the study. The fish in the well plates were extracted using a transfer pipette and placed in a petri dish. The water was discarded into waste, and the well plates were thrown in the trash.
The Zebra Fish in the petri dishes were then observed using a dissecting microscope. Observations were made about their movement in response to a stimulus, their pigmentation and their length. Two fish from each treatment and two from the control were fixed. This was done by place the fish in separate glass vials based on their treatment. They were first anestitized for five minutes, then 2 mL of formaldehyde were added to kill and preserve the fish. These fish will be used to make comparisons between fish development for each treatment on the 8th day and the 15th day.
Observations were also made on Friday February 26th, and Monday February 29th. During these observations each treatment and group and the control group were observed using the dissecting microscope. Again, observations were made about their movement in response to a stimulus, their pigmentation, and their length. Pictures were taken on the 8th day and 12th day.
Results
Conclusion:
No conclusions can be made at this point in time. The only thing of note is that all the metaprolol fish died. This inhibits the study because they cannot be compared to the 7th day fixed fish to the 15th day fixed fish. However two dead metaprolol fish were fixed on the 12th day in order to observe their development up to death. Overall, the study is still ongoing and therefore conclusions have not yet been drawn.
Zebra Fish Experiment Day 1, 2, 5 and 7
2/18/16
Purpose: The purpose of this experiment is to examine any developmental differences that certain toxins may cause. In this experiment, Zebra Fish eggs were placed in epinephrine, metapropol, metapropal and epinephrine mix and deer park water as a control. Throughout two weeks developmental differences between the four groups can be observed to determine the affects of each treatment. It is hypothesized that if metapropol and epinephrine have individual effects on the Zebra Fish, then these effects will either be compounded or, if they are opposite, they will cancel each other out, in the Zebra Fish treated with the mixture of epinephrine and metapropol. Materials and Methods: On day one, 2/18/16, four well-plates were labeled epinephrine, metapropol, epinephrine and metapropol and control. One Zebra Fish egg was placed in each well, with 24 eggs for each treatment. 1 mL of the corresponding treatment was placed into each well using a pipette pump. The eggs were then examined under a dissection microscope in order to stage them.
On two, 2/19/16, new eggs were transferred into four petri dishes due to egg death in the first samples, and one treatment was added to each petri dish. The eggs were again examined under a dissection microscope and staged.
On day five, 2/22/16, the eggs in the well plates were examined under the dissection microscope. The number of dead eggs was counted, the number of live eggs was counted, and the number of hatched fish was counted. One fish had a visible heart beat and the heart rate was recorded. Select individuals were staged, measured and their movements, if they were hatched, were observed and recorded.
On day seven, 2/24/16, the eggs in the well plates and the eggs in the petri dishes were examined under the dissection microscope. The same observations and data for day five were taken. An average size and age were taken for each petri dish and well plate were recorded and the movement patterns were also recorded.
Data and Observations
Table 1: Zebra Fish Data
Day 1:
Average Size: 1 mm
Average Stage: 17 Somite
Day 5:
Control (wells)
WELL B1: 72 hours old, 2.5 mm
WELL C1: 60 hours old, 2 mm
WELL D4: 20 somite, 1 mm
Metapropol (wells)
WELL A1: 60 hours old, 3mm
WELL B4: 48 hours old, 2.5 mm
WELL D3: 60 hours old, 2.5 mm
Epinephrine (wells)
WELL F4: 36 hours old, 1 mm, HB=102 beats per minute
WELL D1: 28 hours old, 1.5 mm
WELL C3: 36 hours old, 1.5 mm
Mix (wells)
WELL C2: 72 hours old, 2.5 mm
WELL B3: 48 hours old, 2 mm
WELL F1: 20 somite
Day 7:
Control (petri)
Average size: 4 mm
Average Stage: Day 5-6
-Lots of darting movements
-Quickly wiggle bodies to move
Metapropol (petri)
Average size: 4 mm
Average Stage: Day 5-6
-Fish lying on sides not moving
-Look close to death
-Less movement than control
-Growth on yolk sack of one fish
-1 bent fish
Epinephrine (petri)
Average size: 4 mm
Average Stage: Day 5-6
-Dark curved hatchling that can’t move forward, just shivered in place
-One not moving but twitches
-Overall movement is similar to control
-1 20-25 somite
Mix (petri)
Average size: 4 mm
Average Stage: Day 5-6
-Dead Hatchling 1- 48 hours old
-Dead Hatchling 2- 60 hours old
-1 fish close to death
-1 20-25 somite
-Overall similar movement to control
Control (wells)
Average size: 3-4 mm
Average stage- Early larval stage (120 hrs)
-7 present body movement
-2 present eye movements only
Metapropol (wells)
Average size: 3-4 mm
Average Stage Early larval stage (120 hrs)
-6 present eye movements only
-5 present movement similar to controls
-1 exhibits spastic movement
Epinephrine (wells)
Average size: 3 mm
Average Stage: Early Larval Stage
-7 present movement similar to control
-2 present slight movement
-1 twitches but can’t go forward
-1 is on his side moving
Mix (wells)
Average size: 3-4 mm
Average Stage: Early larval stage (120 hrs)
-7 present movement similar to control
-6 present eye movement only
Conclusion
No conclusions can be made at this point in time. However, the petri dishes have many more fish that the well plates, which would make them a better study population. It might be most practical going forward to just make observations about the petri dish fish.
Characterizing Invertebrates and Hypothesizing about Vertebrates inhabiting Transect 1 February 11, 2016
Purpose: The purpose of this experiment was to observe the types of invertebrates that were collected from transect 1 by the Berlese funnel. Additionally, the invertebrates were classified by phylum and class in order to determine the types of invertebrates that inhabit transect 1. The other purpose of this lab was to hypothesize what vertebrates might, at times, inhabit transect one and how they fit in the food chain together. Before this lab was begun, it was hypothesized that most of the invertebrates would be arthropods, but among the arthropods there would be diversity.
Materials and Methods: First the Berlese funnel was broken down and the top half of the 50% ethanol and organisms were poured into a petri dish. The rest of the solution was poured into a second petri dish. The dishes were observed by eye and then under the dissecting microscope. Five arthropods were identified using the dichotomous key and the website provided by the TA. Each organism was measured, the number of organisms in the slide was counted, and a picture of the organism was taken. All data was recorded in hand written notes.
After observing the invertebrates, discussion took place in order to determine what types of vertebrates might inhabit transect one. Five vertebrates were identified and they were used to create a food web/chain for transect one. All the other organisms observed in this ongoing observation of transect one were also included in the food web/chain.
Data and Observations
Invertebrates
Table 1: Organisms Observed from Berlese Funnel
Arthropoda Insecta:
-This was the only organism identified in the petri dish with the top half of the berlese funnel liquid poured into it
-The salient features that helped identify it were six legs, antennae, the segmented body and the pointy appendages coming off its back end.
-It was further identified as being of the phylum Arhropoda, the class Insecta and the order Collembola.
Arthropoda Anelida
-The salient features that helped identify it were the segmented body, its lack of legs.
Arthropoda Diplopoda -The salient features identifying this organism were the segmented body and the multitude of short legs that it possessed.
Arthropoda Arachnida -The salient features that helped identify it were the eight legs, the two distinct halves of its body (like a head and a body), and the pincer-like appendages at the end of its head.
Arthropoda Arachnida -This organism is the same phylum and class as the other Arthropoda Arachnida , but it was included because it was classified as a different order. -Its full classification is Arthropoda, Arachnida, Acarina. -The salient features that helped identify it were the oval body, wit a miniscule head in comparison. Also the pointy shape of the head and the stubby, short legs helped identify it as Acarina.
Vertebrates
Based on the known ecology of transect, five vertebrate species were hypothesized to inhabit it, at some point during the year. They are classified below, and the biotic and abiotic factors that would benefit each organism are listed respectively.
Table 2: Possible Vertebrates in Transect 1
Figure 1: Food Web of Organisms Found in Transect 1
This food web represents a basic depiction of the community of organisms that reside in transect 1. At the first trophic levels, primary producers, like photosynthetic bacteria, and plants, convert sunlight and CO2 into energy and carbon compounds. At the second trophic level protists and invertebrates eat the bacteria and plant life. Vertebrates also feed on the plant life, especially the acorns produced by the tree. At the third trophic level the vertebrates and the arachnids feed on other invertebrates. Finally, as all these organisms die, no matter the trophic level, they are decomposed by bacteria and fungi. It becomes clear that the trophic levels are very intertwined into this community of organisms. Furthermore, an environment can only sustain so many organisms before it runs out of resources. This complex matrix of predator and pray ensures that all the populations are kept in relative balance, so long as nothing interferes with the ecosystem. This allows many species to survive, without any of them exceeding the ecosystem's carrying capacity.
Conclusion:
In conclusion, our hypothesis was supported by the data that we collected. The invertebrates found were all arthropods, however four different classes of arthropods were found and five different orders, demonstrating diversity. The arthropods ranged from 1 to 12 mm, again showing diversity. The smallest arthropod was the Arachnida acarina and the largest was the Diploda. The most common arthropod was of the class arachnida (not the acarina), however some of the arachnida were quite large. This would suggest their apparent multitude could just be due to the fact that they were easier to see and detect. In future studies it would be interesting to create depression slides with the Burlese funnel liquid in order to view small invertebrates.
It was also observed that the first half of the liquid observed had very view organisms as most of them had fallen to the bottom of the tube.
Characterizing Monocot and Dicot Plants, Identify Vascularization and Observing Fungi
February 4, 2016
Purpose: The purpose of this experiment was to observe six plant samples from transect 1. This was done to determine whether they are monocot or dicot, whether they have vascularization, and to observe any specialized structures. In additions, samples of fungi were provided for observation and characterization as one of the three fungi groups. Finally, a Berlese funnel was constructed in order to collect invertebrates that will be examined in the next lab session. It is predicted that there will be both monocots and dicots in the transect.
Materials and Methods: First, six plants were identified in the transect to be taken as samples. Their location was noted on the original aerial diagram of transect 1. Then the plants were removed by hand and brought back to the lab. Observations were made and recorded with hand written notes as well as pictures. Measurements of all the samples were taken. The vein structure and root structure were observed in order to classify the plants as monocots and dicots. Vascularization was also characterized for each sample based on the presence of a root system.
After observations were made, cross sections of each plant were made using a razor blade and a depression slide. Pictures of each cross section under the microscope were taken.
There were no seeds in the transect, most likely due to the season. Therefore no observations or cross sections of seeds were possible. In addition there was no evidence of ferns or flowers, indicating a lack of spores. Provided fungi samples were examined using the dissecting microscope and pictures were taken of each.
Finally, a Berlese funnel was set up to collect invertebrates. 25mL of 50:50 ethanol/water into a 50 mL conical tube. Screening material was placed over the bottom of the funnel. a lighted 40 watt lamp was placed above the funnel with the bulb about 1-2 inches from the top of the leaf filter. Everything was covered in foil and left until our next lab session.
Wild Onion Plant
Spiky Plant
Grass
Clover
Large Clover
Root Clump
Small Clover Root Cross Section

Large Clover Stem Cross Section

Leaf Descriptions
Wild Onion Plant
-One Long grass like leaf
-Linear and tubular shape
-68 cm long
Spiky Plant (common Dandelion)
-Basal Leaf arrangement
-Leaves have serrated edges
-Clasping attachment
-Leaf length: 4-6 cm
Grass
-Linear leaves (Blades of grass)
-Arranged in a clump
-Flat blades
-Leaf length: 15 cm
Large Clover
-Leaf length: 3 cm
-Whorled leaf arrangement
-Ovate shape
Clover
-Leaf length: 0.7 cm
-Whorled leaf arrangement
-Obovate shape
Root clump
-No leaves present
Fungi observations
Fungi sporangia are important because they are the structure that a fungus grows in order to reproduce. This sporangium is where meiosis occurs and spores are formed. Once meiosis has occurred the spores are released into the environment. They are carried by water, air, animals etc. They can withstand dry environments and will wait to grow until moisture is available.
All three samples provided for examination were fungi. The first fungus examined was a mushroom, which falls in the group Basidimycota. The second fungus examined was bread mold and falls in the group Zygomycetes. The third sample fell into the category Ascomycota based on the appearance of its mycelium and the sack like structures it produced. (Freeman, 2013)
A picture of the Ascomycota fungi is below. It has a mass of hyphae filaments forming a mycelium, indicating that it is a fungus. In addition there are black sacs that are most likely the ascocarps used for reproduction.
Conclusions: Based on the observations of the samples made, the majority of plant life in transect 1 is vascular. There was a mix of dicot and monocot plants as well, supporting our prediction. In order to get more information on the reproductive strategies of the different samples it would be useful to study different samples during the spring, summer and fall. This would allow further investigation into the types of reproductive strategies as well as what time of year reproduction takes place for each species.
Source:
Freeman, Scott. K, Quillin, L, Allison. (2013). Biological Science. Benjamin Cummings.
Observing Bacteria Using the Microscope and Gram Staining
January 28, 2016
Final Hay Infusion Observation
The hay infusion from transect 1 smells like musty and moldy water, which is a change from last week when there was no detectable smell. There was dry detritus on the sides above the water line, suggesting that the water line had receded due to evaporation. The water had a darker/ murky color. There were more fuzzy organisms growing on sediment. The blade of grass was still green. Finally, there were no more organisms growing on the surface of the water.
It is hypothesized that if there are microorganisms growing in the hay infusion, then they are producing a musty smell through either aerobic, anaerobic respiration or fermentation. Additionally, it is possible that the microorganisms growing on the surface of the water perhaps ran out of food sources, and died off.
Procedure I and II: Quantifying and Observing Microorganisms in Nutrient Agar and Nutrient Agar + Tetracycline
Table 1: 100-fold Serial Dilutions Results
The 10^-3 Nutrient plate had more diversity in the types of bacteria than the 10^-3 Nutrient + Tetracycline plate. On the nutrient plate there were purple, white, white-clear, yellow and orange colonies. The colonies were, on average larger than those on the tetracycline plate of the same dilution. On the Tetracycline plate of the 10^-3 dilution there are smaller orange colonies and one small, pale yellow colony. There was one similar orange colony viewed on the Nutrient 10^-3 dilution.
On the 10^-5 dilution with just nutrient there are ten colonies (although only 4 are visible in the picture). They include the yellow, white and white-clear colonies that were observed on the Nutrient 10^-3 plate. The Nutrient + Tetracycline plate of the same dilution has no colonies. The rest of the plates at greater dilutions have no visible colonies.
This shows that a more diverse population of bacteria was able to live in the plate with just nutrients. Also, less overall colonies of bacteria survive when tetracycline is present. Furthermore, the small orange colonies were scarce in the nutrient10^-3 plate and non-existent in the rest of the nutrient plates. However, once competition from other bacteria colonies was eliminated by the tetracycline, the small orange bacteria thrived and produced many colonies.
Pictures of the first and second dilution plates are below. Pictures of the second and third dilution plates were not included as there were no visible bacteria colonies. *Note: the pictures appear too large but if they are clicked on then it is possible to view them in a normal size.
There were most likely not any Archaea species growing in the hay infusion or the cultures made from it because Archaea tend to grow in harsh environments. A transect on AU and its subsequent hay infusion is not a harsh enough environment.
Nutrient Agar Plate: Serial Dilution 1

Nutrient + Tetracycline Plate: Serial Dilution 1
Nutrient+Tetracycline Plate Dilution 2 (left), Nutrient Agar Plate Dilution 2 (right)

Tetracycline is a broad range antibiotic that functions against gram-positive bacteria, gram-negative bacteria, chlamydiae, mycoplasmas, rickettsiae, and protozoan parasites. It has been used in treatment, as well as in animal feed, and because of this overuse, many bacteria and parasites have developed immunity to it. Tetracycline works by preventing bacterial protein synthesis. It does this by stopping the aminoacyl-tRNA from associating with the bacterial ribosome. Several methods of antibiotic resistance have been documented including bacteria with new genes that code for energy-dependent efflux of tetracycline or that code for a protein that protects bacterial ribosomes. Some bacteria have had gene mutations that alter the permeability of the out membrane, which prohibits tetracycline from entering the cell (Chopra, 2001).
Procedure III: Bacteria Cell Morphology Observations and Gram Staining of Bacteria
Table 2: Bacteria Characterization
White Bacteria Colony, Unstained

White Bacteria Colony, Stained

Purple Bacteria Colony, Unstained

Purple Bacteria Colony, Stained

Orange Bacteria Colony, Unstained

Orange Bacteria Colony, Stained

Yellow Bacteria Colony, Unstained

Yellow Bacteria Colony, Stained

Observing Protists and Algae in the Hay Infusion from Transect 1
January 21, 2016
Purpose: The purpose of this experiment was to observe the hay infusion that was taken from transect 1, one week ago. The hay infusion was observed on a macro scale, and cultures were made from the hay infusion in order to observe the protists and algae present. Finally, serial dilutions were plated in agar plates in preparation for observing prokaryotes and fungi next week.
Materials and Methods: First, the hay infusion was observed and hand written notes as well as pictures were taken to record its appearance. The scent, and the presence of life at the surface, in the middle and near the bottom were noted. A drop of water was taken from the surface of the water, from just above the bottom of the jar and from the water surrounding some suspended sediment that was observed. Each drop was taken with a different transfer pipet and placed on a separate slide. Then a drop of Proto Slow was added to each slide and a cover slip was put on top of the liquid. Each slide was examined using a microscope and several protists and algae were identified using the dichotomous keys provided. All the observations and identifications were recorded with hand written notes and pictures.
After the hay infusion was observed, eight serial dilutions were made. This was done by adding 100 microliters of the hay infusion water to 10 milliliters of the broth. This was mixed and then 100 microliters were taken from it and added to another tube with 10 milliliters of broth. This was repeated four times resulting in four tubes that contained 10^-2, 10^-4, 10^-6 and 10^-8 dilution. Two samples of 100 microliters were taken from each tube and one sample was deposited on a nutrient agar plate and the other was deposited on nutrient plus tetracycline (antibiotic) plate. Each was labeled and put away to be observed next week.
Data and Observations:
Description of Hay Infusion—The hay infusion had no detectable smell. There was a gray film on the surface that was distributed in a way that looked like colonies of bacteria. All the sediment including soil, sticks and grass had settled to the bottom except for a few pieces of sediment and one blade of grass that were suspended from the surface of the water. The suspended sediment had fuzzy looking organisms growing on it. There were red-brown organisms growing on the bottom centimeter of the jar walls. The water had a murky green tint. On the sides of the jar above one centimeter there were green organisms growing, probably algae.


Description of Slide 1— Slide 1 was taken from the water just above the sediment at the bottom of the jar. 3 organisms were identified. A Paramecium multimicronucleatum, 300 micrometers in length was observed and more than four Paramecium multimicronucleatum were observed in the samples. These organisms moved fast, were a green color, oval in shape and had cilia around the edge used to propel them. A Gloeocapsa, 300 micrometers in length was also identified. A larger organism, Oscillatoria, surrounded this organism. The Gleocapsa and Oscillatoria were both non-motile. All three organisms are protists.
 Description of Slide 2— Slide 2 was taken from the surface of the water in the hay infusion. A Paramecium bursaria, 50 micrometers in length was identified. This organism was also very motile.
Description of Slide 2— Slide 2 was taken from the surface of the water in the hay infusion. A Paramecium bursaria, 50 micrometers in length was identified. This organism was also very motile.
 Description of Slide 3— Slide 3 was taken from the water surrounding the suspended sediment. A Peranema, 50 micrometers in length was identified and a Euplotes, 100 micrometers in length was identified. Both are protists.
Description of Slide 3— Slide 3 was taken from the water surrounding the suspended sediment. A Peranema, 50 micrometers in length was identified and a Euplotes, 100 micrometers in length was identified. Both are protists.

Paramecium multimicronucleatum- This organism meets all the needs of life, including acquiring energy, containing a cell/cells, being able to store information, being able to replicate and being able to evolve. The Paramecium acquires energy by ingesting other organism like algae and bacteria. It has a cytostome which allows food to enter the cell. A Paramecium is a single celled organism, therefore it does have a cell, including a cell wall and protoplasm inside. Inside the paramecium cell, DNA is contained which both stores genetic information and allows for this information to be passed on to offspring. Paramecium reproduce through binary fission, meaning everything inside the cell duplicates, including the DNA, and then the cell splits down the middle to form two separate Paramecium. Because Paramecium reproduce and their DNA can mutate, this means that natural selection can act on the genetic variability within a population and cause evolution over generations (http://www.fcps.edu/islandcreekes/ecology/paramecium.htm).
Conclusions: Based on the observations made, there are many different forms of protists present in the Hay Infusion. In future studies it would be prudent to make a larger effort to identify algae. Furthermore, if the hay infusion were to grow for another two months, it is predicted that more plants would start to grow. Also, since, it is a limited space with limited resources, some species my out compete others in the hay infusion. This could cause a loss of diversity.
-KW
Observing Biodiversity in an Ecosystem: AU Transect 1
January 14, 2016
Purpose: The purpose of this experiment was to observe the biodiversity present in a 20 foot by 20 foot transect on American University’s grounds. In addition to observing the transect, a hay infusion was taken in order to see the different protists and invertebrates in the transect. It is hypothesized that there will be protists and invertebrates present in the hay infusion.
Materials and Methods: First, transect 1 was observed on the macro scale and hand written notes were taken to record the data. The number and type of both biotic and abiotic items were recorded. 19 pictures were also taken of the landscape to record the data. In addition, a sketch of an aerial-view diagram of the transect was drawn.
After observations were made, a sample of the topmost layer of soil, leaves, rocks and other material was put into a plastic bag and brought back to the lab. There, 12 grams of the soil sample was put into a plastic jar with 500 mLs of deerpark water, and 0.1 grams of dried milk. The deerpark water was measured using a graduated cylinder and the dried milk powder and soil sample were weighed separately, using a scale. The mixture was shaken up and left with the lid open to sit for 1 week.
Data and Observations: Description of Transect 1-- Transect 1 is located between Hurst building and Ward Circle building. The north side of the transect is bordered by a concrete wall, the east side is bordered by a concrete sidewalk, the south side is bordered by pavement and the east side is an extension of the plant bed that is the transect. The topography of the transect is relatively flat. There are two large trees, about four stories high, that have nearly bare branches with some dead leaves that appear to be oak leaves. on the trunks of these trees there are large nodules that could possible be growths of some kind. There are also many smaller trees in the transect. They are characterized by thin bare branches that all grow out of the ground in one cluster rather than sprouting from a shared trunk. Additionally in the southeast corner, and around the middle of the transect there are patches of green grass that is about 6 inches long. The ground is littered with half eaten acorns, maybe by squirrels, dead leaves, a pine branch, several rocks and branches. Underneath this is soil. There are also small, green, leafy plants that grow close to the ground around the east side of the transect as well as these dead looking root tufts. The tufts are short and round with branches sticking out. There are also several sprinkler heads spaced throughout the transect. On the east side, concrete sidewalk makes up part of the transect.
Biotic Organisms Observed: -Clover like plants -Acorns -Roots -Large trees -Small bush trees (about 2 meters high) -Grass clumps -Eaten seed chunk -Pine tree branch -Growth on tree possibly -Sticks -Dead leaves -Bark
Abiotic Items Observed: -Soil -Rocks -Sprinkler heads -Lamp post -Sidewalk
Possible Competitive Relationships in Transect 1: -Squirrel eating the acorns (squirrel competes with oak tree)
-- could also be symbiotic
-Plants competing for space and nutrients in soil
Possible Symbiotic Relationships: -Squirrel living in oak tree and spreading the acorns -Fungus/bacteria decomposing detritus making soil richer
Transect 1 Aerial Diagram
Link to photos
Conclusions Based on the observations made, there is a large amount of biodiversity in the plot even without the results of the hay infusion. It would be interesting to do further investigation into what types of organisms exactly are in the transect rather the just describing them. Also, it would be interesting to see if there is a growth on the large oak tree and if so what it is. Our hypothesis cannot yet be addressed because the hay infusion won't be examined until the next lab.
-KW
1/17/16 First Post
Hi, just doing my first post.
-KW































